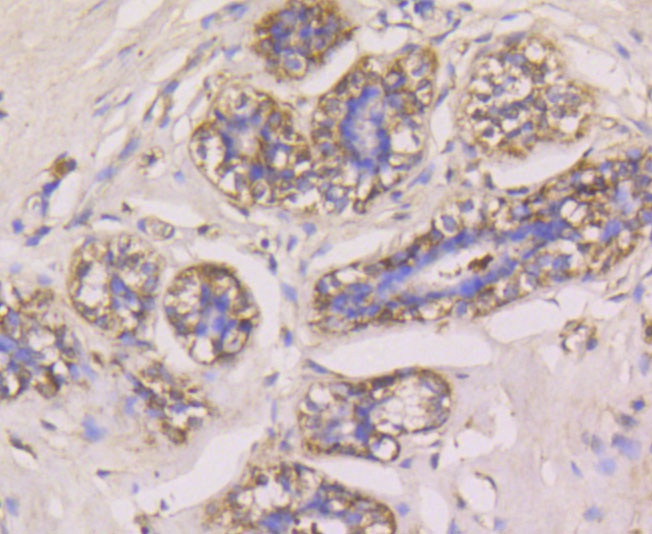
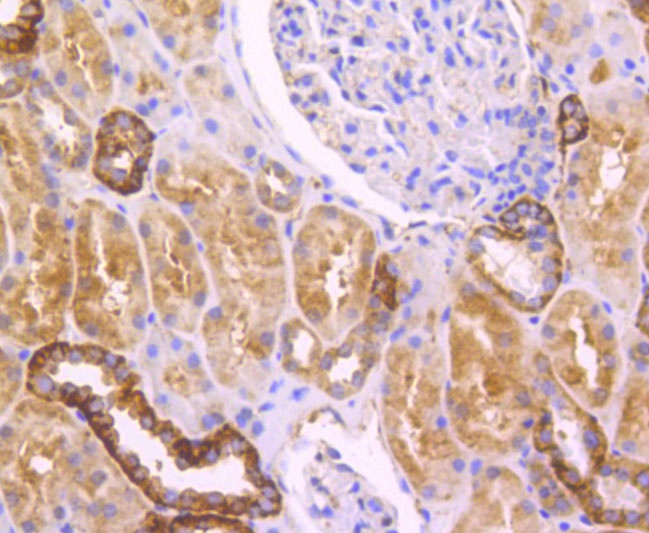

Rmb: 618 1500 特惠 1500
产品规格
Safety datasheet
概述
产品名称
Glutathione Peroxidase 1 Rabbit Polyclonal Antibody
抗体类型
Rabbit Polyclonal Antibody
免疫原
Synthetic peptide within C-terminalhuman Glutathione peroxidase 1.
种属反应性
Human, Mouse
验证应用
WB, IF-Cell, IHC-P, FC
分子量
Predicted band size: 22 kDa
阳性对照
Mouse liver tissue, human liver tissue, 293T, human breast cancer tissue, human kidney tissue, mouse brain tissue, HepG2.
偶联
unconjugated
RRID
产品特性
形态
Liquid
浓度
存放说明
Shipped at 4℃. Store at +4℃ short term (1-2 weeks). Store at -20℃ long term.
存储缓冲液
1*PBS (pH7.4), 0.2% BSA, 40% Glycerol. Preservative: 0.05% Sodium Azide.
亚型
IgG
纯化方式
Immunogen affinity purified.
应用稀释度
-
WB
-
1:500-1:1,000
-
IF-Cell
-
1:100-1:200
-
IHC-P
-
1:50-1:200
-
FC
-
1:50-1:100
靶点
功能
Glutathione peroxidase (GPx) enzymes are generally selenium-containing tetrameric glycoproteins that help prevent lipid peroxidation of cell membranes. GPx enzymes reduce lipid hydroperoxides to alcohols, and reduce free hydrogen peroxide to water. GPx members are among the few proteins known in higher vertebrates to contain selenocysteine, which occurs at the active site of glutathione peroxidase and is coded by the nonsense (stop) codon TGA. There are eight GPx homologs (GPx-1-8). GPx-1, Gpx-2 and Gpx-3 exist as homotetramers. Gpx-4 has a high tendancy to form high molecular weight oligomers. GPx-1 plays an important role in the antioxidant defense of the vascular wall and neural cells in response to oxidative stress. GPx-2 is the major isoform in the lungs and its basal or inducible expression is dependent on Nrf2. GPx-3 is under regulation by hypoxic stress and the expression and deficiency of GPx-3 is associated with cardiovascular disease and stroke. GPx-5 is selenium-independent; it is bound to the acrosome of sperm, where it may protect sperm from premature acrosome reaction in the epididymis.
背景文献
1. Crilly MJ et al. The role of Nrf2 in skeletal muscle contractile and mitochondrial function. J Appl Physiol (1985) 121:730-40 (2016).
2. Di Filippo C et al. Daily Oxygen/O3 Treatment Reduces Muscular Fatigue and Improves Cardiac Performance in Rats Subjected to Prolonged High Intensity Physical Exercise. Oxid Med Cell Longev 2015:190640 (2015).
序列相似性
Belongs to the glutathione peroxidase family.
组织特异性
Expressed in platelets (at protein level).
翻译后修饰
During periods of oxidative stress, Sec-49 may react with a superoxide radical, irreversibly lose hydroselenide and be converted to dehydroalanine.
亚细胞定位
Cytoplasm.
别名
AL033363 antibody
Cellular glutathione peroxidase antibody
Glutathione peroxidase 1 antibody
Glutathione peroxidase antibody
GPx 1 antibody
GPx-1 antibody
GPX1 antibody
GPX1_HUMAN antibody
GPXD antibody
GSHPx-1 antibody
展开AL033363 antibody
Cellular glutathione peroxidase antibody
Glutathione peroxidase 1 antibody
Glutathione peroxidase antibody
GPx 1 antibody
GPx-1 antibody
GPX1 antibody
GPX1_HUMAN antibody
GPXD antibody
GSHPx-1 antibody
GSHPX1 antibody
MGC14399 antibody
MGC88245 antibody
折叠图片
-

ICC staining Glutathione Peroxidase 1 in 293T cells (green). Formalin fixed cells were permeabilized with 0.1% Triton X-100 in TBS for 10 minutes at room temperature and blocked with 1% Blocker BSA for 15 minutes at room temperature. Cells were probed with the antibody (R1401-12) at a dilution of 1:100 for 1 hour at room temperature, washed with PBS. Alexa Fluorc™ 488 Goat anti-Rabbit IgG was used as the secondary antibody at 1/100 dilution.
-

Immunohistochemical analysis of paraffin-embedded human liver tissue using anti-Glutathione Peroxidase 1 antibody. The section was pre-treated using heat mediated antigen retrieval with Tris-EDTA buffer (pH 8.0-8.4) for 20 minutes.The tissues were blocked in 5% BSA for 30 minutes at room temperature, washed with ddH2O and PBS, and then probed with the antibody (R1401-12) at 1/200 dilution, for 30 minutes at room temperature and detected using an HRP conjugated compact polymer system. DAB was used as the chromogen. Counter stained with hematoxylin and mounted with DPX.
-

Immunohistochemical analysis of paraffin-embedded human breast cancer tissue using anti-Glutathione Peroxidase 1 antibody. The section was pre-treated using heat mediated antigen retrieval with Tris-EDTA buffer (pH 8.0-8.4) for 20 minutes.The tissues were blocked in 5% BSA for 30 minutes at room temperature, washed with ddH2O and PBS, and then probed with the antibody (R1401-12) at 1/50 dilution, for 30 minutes at room temperature and detected using an HRP conjugated compact polymer system. DAB was used as the chromogen. Counter stained with hematoxylin and mounted with DPX.
-
Immunohistochemical analysis of paraffin-embedded human kidney tissue using anti-Glutathione Peroxidase 1 antibody. The section was pre-treated using heat mediated antigen retrieval with Tris-EDTA buffer (pH 8.0-8.4) for 20 minutes.The tissues were blocked in 5% BSA for 30 minutes at room temperature, washed with ddH2O and PBS, and then probed with the antibody (R1401-12) at 1/200 dilution, for 30 minutes at room temperature and detected using an HRP conjugated compact polymer system. DAB was used as the chromogen. Counter stained with hematoxylin and mounted with DPX.
-
Immunohistochemical analysis of paraffin-embedded mouse liver tissue using anti-Glutathione Peroxidase 1 antibody. The section was pre-treated using heat mediated antigen retrieval with Tris-EDTA buffer (pH 8.0-8.4) for 20 minutes.The tissues were blocked in 5% BSA for 30 minutes at room temperature, washed with ddH2O and PBS, and then probed with the antibody (R1401-12) at 1/200 dilution, for 30 minutes at room temperature and detected using an HRP conjugated compact polymer system. DAB was used as the chromogen. Counter stained with hematoxylin and mounted with DPX.
-

Immunohistochemical analysis of paraffin-embedded mouse brain tissue using anti-Glutathione Peroxidase 1 antibody. The section was pre-treated using heat mediated antigen retrieval with Tris-EDTA buffer (pH 8.0-8.4) for 20 minutes.The tissues were blocked in 5% BSA for 30 minutes at room temperature, washed with ddH2O and PBS, and then probed with the antibody (R1401-12) at 1/100 dilution, for 30 minutes at room temperature and detected using an HRP conjugated compact polymer system. DAB was used as the chromogen. Counter stained with hematoxylin and mounted with DPX.
-

Flow cytometric analysis of Glutathione Peroxidase 1 was done on HepG2 cells. The cells were fixed, permeabilized and stained with Glutathione Peroxidase 1 antibody at 1/100 dilution (red) compared with an unlabelled control (cells without incubation with primary antibody; black). After incubation of the primary antibody on room temperature for an hour, the cells was stained with a Alexa Fluor™ 488-conjugated goat anti-rabbit IgG Secondary antibody at 1/500 dilution for 30 minutes.
请注意: All products are "FOR RESEARCH USE ONLY AND ARE NOT INTENDED FOR DIAGNOSTIC OR THERAPEUTIC USE"
Alternative Products
同靶点 & 同通路的产品
Glutathione peroxidase 1 Recombinant Mouse Monoclonal Antibody [C5-A10-R]
Application: WB,IF-Cell,IHC-P,FC
Reactivity: Human
Conjugate: unconjugated
Glutathione peroxidase 1 Mouse Monoclonal Antibody [C5-A10]
Application: WB,IF-Cell,FC,IHC-P
Reactivity: Human,Mouse
Conjugate: unconjugated
Glutathione peroxidase 1 Mouse Monoclonal Antibody [A6-C0-B9]
Application: WB,IHC-P,FC,IF-Cell
Reactivity: Human
Conjugate: unconjugated
Glutathione peroxidase 1 Recombinant Mouse Monoclonal Antibody [A6-C0-B9-R] - BSA and Azide free
Application: WB,IF-Cell,IHC-P,FC
Reactivity: Human
Conjugate: unconjugated
Glutathione Peroxidase 1 Recombinant Rabbit Monoclonal Antibody [JF0944]
Application: WB,IF-Tissue,IHC-P
Reactivity: Human,Mouse
Conjugate: unconjugated
Glutathione Peroxidase 1 Mouse Monoclonal Antibody [C5-F6]
Application: WB,IF-Cell,IHC-P,FC
Reactivity: Human
Conjugate: unconjugated
Glutathione peroxidase 1 Recombinant Mouse Monoclonal Antibody [C5-A10-R] - BSA and Azide free
Application: WB,IF-Cell,IHC-P,FC
Reactivity: Human
Conjugate: unconjugated
Glutathione peroxidase 1 Recombinant Mouse Monoclonal Antibody [A6-C0-B9-R]
Application: WB,IF-Cell,IHC-P,FC
Reactivity: Human
Conjugate: unconjugated
Glutathione Peroxidase 1 Recombinant Rabbit Monoclonal Antibody [JJ092-07]
Application: WB,IP
Reactivity: Human,Mouse,Rat
Conjugate: unconjugated












 浙公网安备 33019202000643号
浙公网安备 33019202000643号